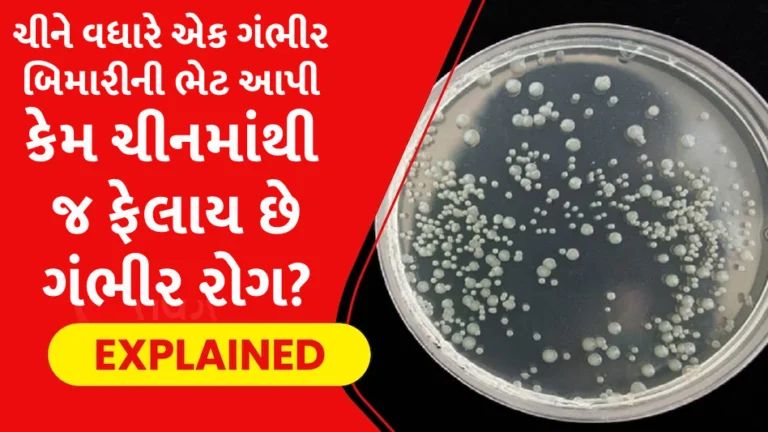
ચીનમાંથી ફેલાઇ રહી છે બાળકોની વધારે એક ગંભીર બિમારી, સમગ્ર વિશ્વમાં ફેલાઇ ચિંતા gujarattak

ચીનમાંથી ફેલાઇ રહી છે બાળકોની વધારે એક ગંભીર બિમારી, સમગ્ર વિશ્વમાં ફેલાઇ ચિંતા
નવી દિલ્હી : કોરોનાને કારણે ચીનથઈ એક તરફ ડરાવના સમાચાર આવી રહ્યા છે. ત્યાં બાળકોમાં રહસ્યમયી બિમારી જોવા મળી રહી છે, જેના લક્ષણ ન્યૂમોનિયા જેવા…
ADVERTISEMENT
નવી દિલ્હી : કોરોનાને કારણે ચીનથઈ એક તરફ ડરાવના સમાચાર આવી રહ્યા છે. ત્યાં બાળકોમાં રહસ્યમયી બિમારી જોવા મળી રહી છે, જેના લક્ષણ ન્યૂમોનિયા જેવા હોય છે. WHO એ ચીનથી બિમારીની માહિતી મંગાવવા ઉપરાંત માહિતી જાહેર કરી છે. આ સાથે જ ખોફ વધી રહ્યો છે કે, શું ચીન એકવાર ફરીથી શ્વાસને લગતી એક ખતરનાક બીમારી વિશ્વને આપવાનો છે.
ચીન ફરી એકવાર બિમારી અને ડેટા છુપાવી રહ્યું છે
રહસ્યમયી ન્યૂમોનિયાના દર્દીઓ ચીનના ઉત્તર-પૂર્વી બીજિંગ અને લિયાઓનિંગના હોસ્પિટલમાં જોવા મળી રહ્યા છે. બાળકોમાં ભારે તાવ, ઉધરસ અને શ્વાસ લેવામાં સમસ્યા જેવા લક્ષણ છે, જે ન્યૂમોનિયાની જેમ છે. કોરોનામાં પણ આ પ્રકારના સંકેત હોય છે, જો કે અત્યાર સુધી બાળકો આ મહામારીથી દુર જ રહ્યા હતા.
કોવિડ જ બાળકો પર આક્રમક કરી રહ્યું છે
બીજી તરફ સવાલ ઉઠી રહ્યો છે કે, શું કોવિડ જ નવા સ્વરૂપે આ વખતે બાળકો પર હુમલો કરી રહ્યો છે, કે પછી ચીનના કારણે કોઇ નવો વાયરસ પેદા થઇ ચુક્યો છે. અત્રે ઉલ્લેખનીય છે કે, કોરોના પણ ચીનના કારણે જ ફેલાયો હતો. તે વુહાન માર્કેટ અથવા તો લેબમાંથી લીક થયો હોવાની એક માન્યતા છે. ગ્લોબલ સંસ્થાઓનું માનવું છે કે, મોટા ભાગની મહામારીઓની શરૂઆત આફ્રીકા અથવા એશિયન દેશો સાથે થાય છે. WHO ના ડિસીઝ આઉટબ્રેકમાં પણ આ વાત સ્વિકારવામાં આવી છે. આ ગ્લોબલ સ્તર પર જાણીતી કે અજાણી બીમારીઓ અંગે વાત કરે છે.
ADVERTISEMENT
કઇ કઇ બિમારીઓ આવી
મંકી પોક્સ, જીકા વાયરસ, ઇબોલા વાયરસ, સાર્સ, માર્સ અને હાલમાં જ તબાહી મચાવી ચુકેલો વાયરસ. આ તમામ બીમારીઓનું ઓરિજિન એશિયા અને આફ્રીકા છે. ખાસ કરીને શ્વાસ અંગેની બિમારીઓની શરૂઆત ચીનથી જ કનેક્ટેડ દેખાય છે. જો કે આ અંગે કોઇ પૃષ્ટી થઇ શકી નથી.
ADVERTISEMENT